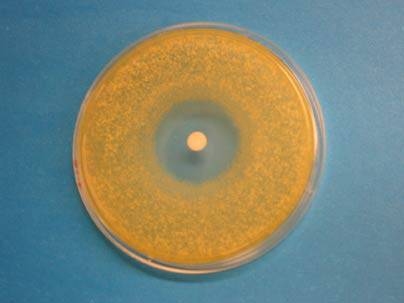

War may actually be healthy for you (war between two microscopic bugs, that is).
MIT biologists have provoked soil-dwelling bacteria into producing a new type of antibiotic by pitting them against another strain of bacteria in a battle for survival.
The antibiotic holds promise for treatment of Helicobacter pylori, which causes stomach ulcers in humans. Also, figuring out the still-murky explanation for how the new antibiotic was produced could help scientists develop strategies for finding other new antibiotics.
The work is reported in the February issue of the Journal of the American Chemical Society.
A combination of luck, patience and good detective work contributed to the discovery of the new antibiotic, according to Philip Lessard, research scientist in Professor Anthony Sinskey's laboratory at MIT.
Sinskey's lab has been studying Rhodococcus, a type of soil-dwelling bacteria, for many years. While sequencing the genome of one Rhodococcus species, the researchers noticed that a large number of genes seemed to code for secondary metabolic products, which are compounds such as antibiotics, toxins and pigments.
However, Rhodococcus does not normally produce antibiotics. Many bacteria have genes for antibiotics that are only activated when the bacteria are threatened in some way, so the researchers suspected that might be true of Rhodococcus.
Kazuhiko Kurosawa, a postdoctoral associate in the Department of Biology, decided to try to provoke the bacteria into synthesizing antibiotics by placing them in stressful environments. He tried turning the temperature up and down, then altered the bacteria's growth medium, but nothing worked.
Kurosawa then decided to stress the Rhodococcus bacteria by forcing them to grow in the presence of competing bacteria, a strain of Streptomyces. Streptomyces produces an antibiotic that normally kills other bacteria, but in one of the experimental test tubes, Rhodococcus started producing its own antibiotic, which wiped out the Streptomyces.
The researchers isolated the antibiotic, dubbed it rhodostreptomycin and started testing it to see what else it would kill. It proved effective against many other strains of bacteria, most notably Helicobacter pylori. Rhodostreptomycin is a promising candidate to treat H. pylori because it can survive in very acidic environments such as the stomach.
The antibiotic turned out to be a type of molecule called an aminoglycoside, composed of peculiar sugars, one of which has a ring structure that has not been seen before. The ring structure could offer chemists a new target for modification, allowing them to synthesize antibiotics that are more effective and/or stable.
"Even if [rhodostreptomycin] is not the best antibiotic, it provides new structures to make chemical derivatives of," said Lessard. "This may be a starting point for new antibiotics."
One mystery still to be solved is why Rhodococcus started producing this antibiotic. One theory is that the presence of the competing strain of bacteria caused Rhodococcus to "raise the alarm" and turn on new genes.
The version of Rhodococcus that produces the antibiotic has a "megaplasmid," or large segment of extra DNA, that it received from Streptomyces. A logical conclusion is that the plasmid carries the gene for rhodostreptomycin, but the researchers have sequenced more than half of the plasmid and found no genes that correlate to the antibiotic.
Another theory is that the plasmid itself served as the "insult" that provoked Rhodococcus into producing the antibiotic. Alternatively, it is possible that some kind of interaction of the two bacterial genomes produced the new antibiotic.
"Somehow the genes in the megaplasmid combined with the genes in Rhodococcus and together they produced something that neither parent could make alone," said Lessard.
If scientists could figure out how that happens, they could start to manipulate bacterial genomes in a more methodical fashion to design new antibiotics.
Other authors of the paper are T.G. Sambandan, research scientist in MIT's Department of Biology, MIT professors Anthony Sinskey of biology and ChoKyun Rha of the Biomaterials Science and Engineering Laboratory, and Ion Ghiviriga and Joanna Barbara of the University of Florida.
The research was funded by the Cambridge-MIT Institute and the Malaysia-MIT Biotechnology Partnership Program.
A version of this article appeared in MIT Tech Talk on February 27, 2008 (download PDF).